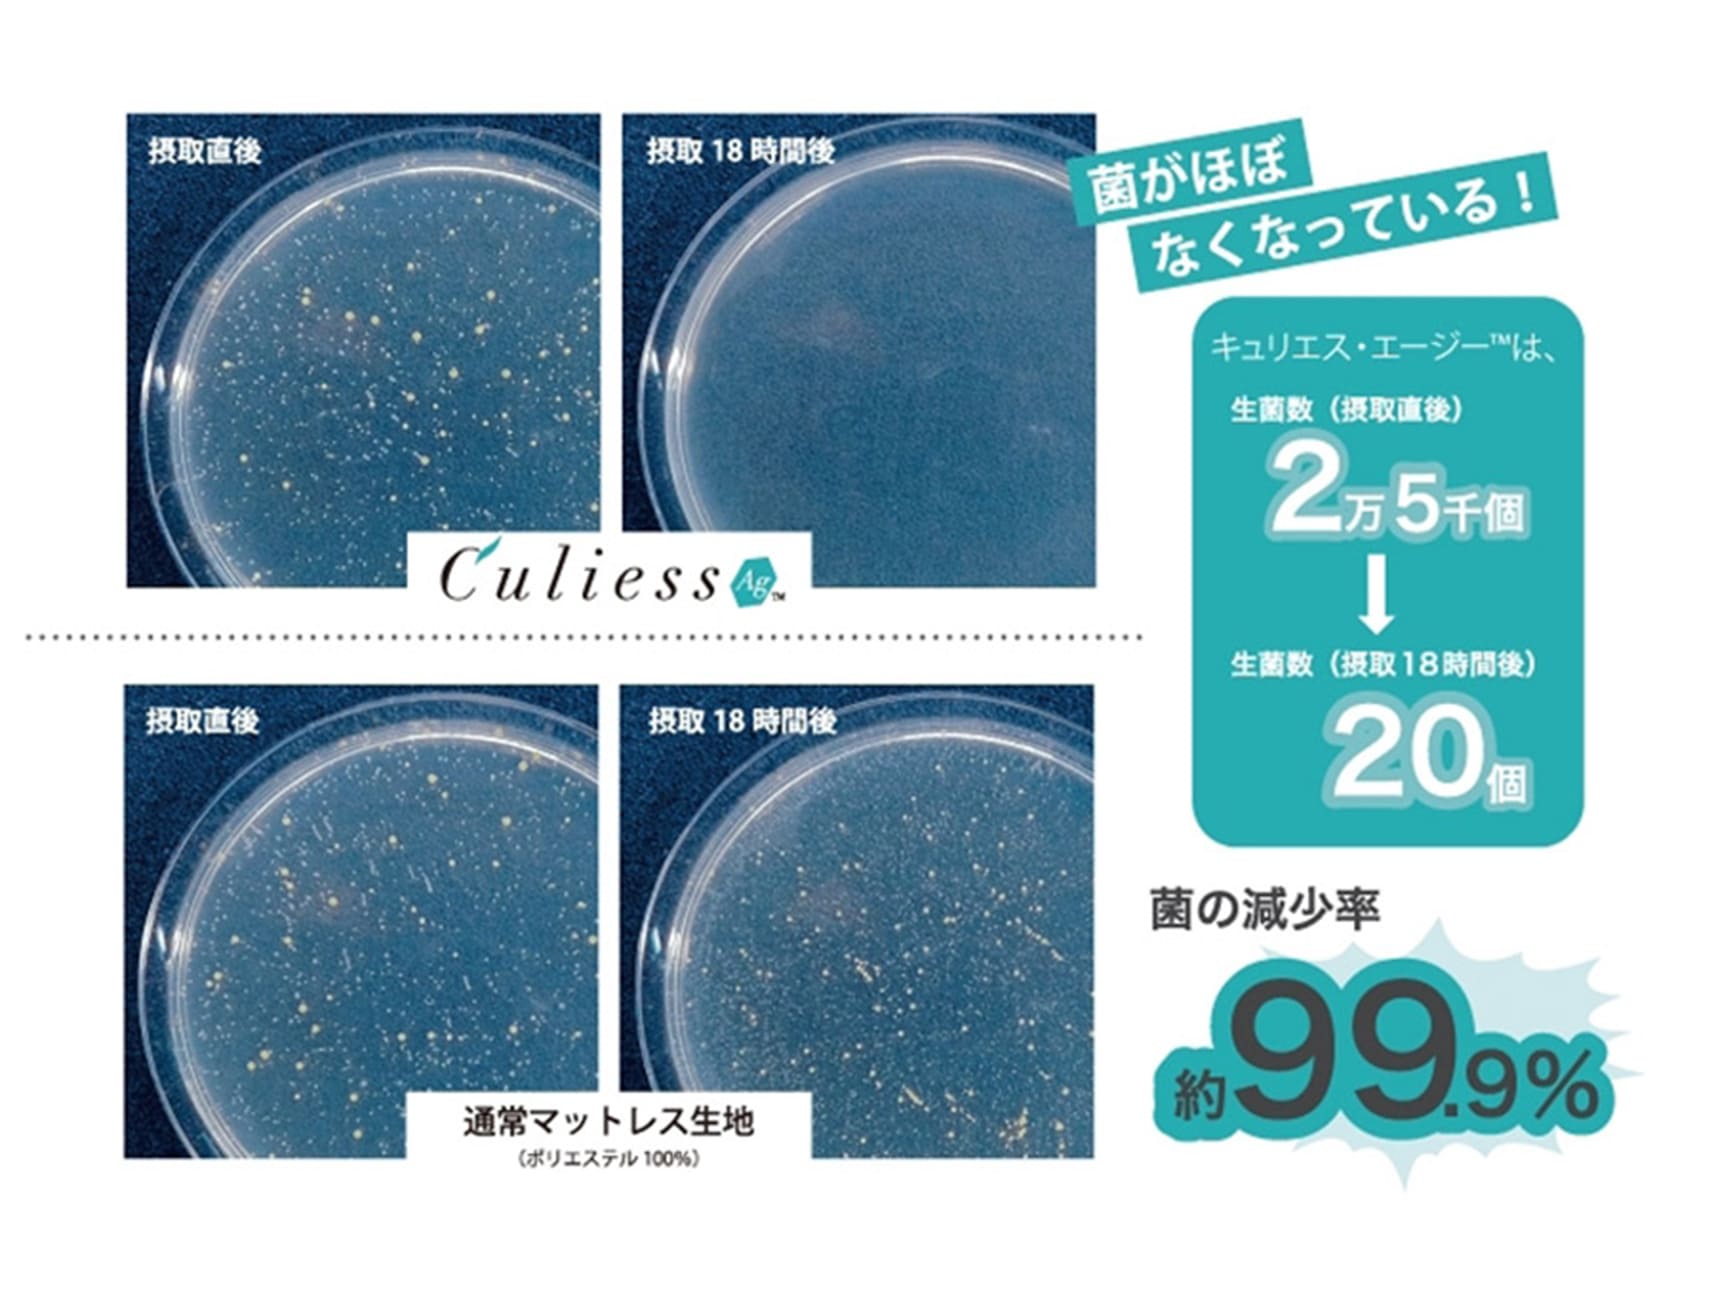

ソファベッド
ソファベッド
3次元スプリング構造体の新素材ブレスエアーエクストラ®搭載。抜群の通気性、高い耐久性、ふとん乾燥機(低温)もOK。高反発クッションで身体をサポートし理想的な寝姿勢を保ちます。また、寝返りしやすいのが特徴です。除菌機能糸「AGliza®」は、時間の経過とともに菌を減少、99.9%除菌します。悪臭などの原因となる菌11種類への効果があり、高温多湿な日本の寝具の衛生面をサポートします。気になる寝室の臭いに効果的です。
詳細情報
| 商品コード | 1002289300001(ショート/ハイタイプ/ブルー) 1002289300002(ショート/ハイタイプ/ベージュ) 0703122000000(レギュラー/ハイタイプ/ブルー) |
|---|---|
| サイズ | ショート 幅170cm(レッグ無し) ショート 幅170cm(ロー・ハイ) レギュラー 幅190cm(レッグ無し) レギュラー 幅190cm(ロー・ハイ) |
| 材質・仕様など | [共通サイズ] D920(ベッド時1100)×H700/785/840 × SH300/375/430(mm) [側生地] ポリエステル79%、綿19%、アクリル2%、除菌機能糸アグリーザ®使用 [クッション材]高密度連続スプリング® /ブレスエアーエクストラ® [重量]ショート44kg / レギュラー46kg |
| 特記事項 | お取り寄せ商品 |